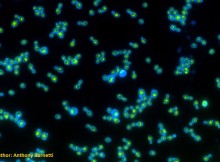

Наука Archive
Наука
Београд: Иако је постојало до сада више пројектних предлога за финансијском помоћи од државног или приватног сектора, Србија, до сада, није лансирала сателит у Земљину орбиту и тиме
Read More
Наука
Observations of galaxy M87 show how the black hole at its centre relates to a long-seen stream of superheated matter. The first image of a black hole wowed
Read More
Наука
Members of the departing editorial teams say that the fees to publish articles are unsustainable. More than 40 editors have resigned from two leading neuroscience journals in protest
Read More
Друштво
Plan to expand irrigation draws fierce criticism A plan to expand irrigated farming around one of Europe’s most important wetlands has alarmed conservation scientists and European officials. They
Read More
Наука
Experiments show ease by which organisms can evolve the ability to harness sunlight for energy Atlanta, USA: Yeast are carb lovers, sustaining themselves by fermenting sugars and starches
Read More

Власник сајта: HR2RENT - део слагалице који Вам недостаје
Власник сајта: HR2RENT - део слагалице који Вам недостаје